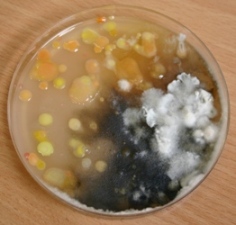

Hors ligne

Hors ligne

Hors ligne

mais je me demander car je n'avait jamais vue non plus un jaune aussi vif je l'ai inoculer avec une seringue de spore tous a coter d un bec benzen pour éviter le contamination tous stériliser après y avait t'il une petite chose qui c'est glisser sur la seringue entre 2 injection ... je n sais pas mais se qui le plus troublant c'est que il n'y en a qu un seul coter et j'ai donc fit nue 2 ene de substrat que j'ai inoculer et c'est le seul avec cette anomalie Dernière modification par watcha789 (24 janvier 2019 à 17:22)
Hors ligne

Dernière modification par watcha789 (24 janvier 2019 à 17:23)
Hors ligne

Hors ligne